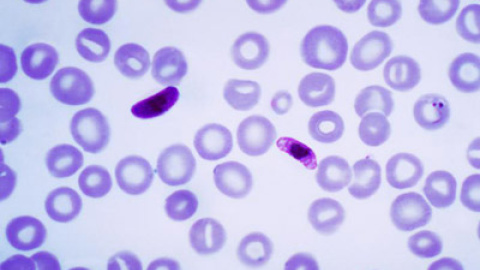

Este artículo se publicó hace 15 años.
España y Portugal llevaron la malaria a Suramérica
Un nuevo estudio aporta pruebas concluyentes sobre cómo y cuándo entró la malaria en Suramérica. Como ya proponían otros trabajos, dice que la enfermedad llegó a bordo de barcos que transportaban esclavos entre el continente negro y los puertos españoles y portugueses en América. Los 300 años de viajes negreros de uno a otro extremo del Atlántico impulsados por estas dos naciones son los responsables de las variantes de malaria que existen hoy en día en Suramérica, según un estudio dirigido por el español Francisco Ayala, que trabaja en la Universidad de California en Irvine.
Un nutrido equipo con investigadores de 15 países ha analizado más de 500 muestras de sangre humana infectada recogidas en 17 países de África, Asia y Suramérica. El análisis genético permite reconstruir el avance de la enfermedad desde su origen africano. Estudios previos de este tipo han permitido comprobar que la malaria pasó de simios a humanos o apuntar que hace 6.000 años la dolencia experimentó "un rápido avance debido al auge de la agricultura", según el trabajo, publicado en PNAS.
El análisis ha encontrado dos variantes principales de malaria en Suramérica, una para cada nación conquistadora. "La subdivisión de las Américas en dos imperios y el hecho de que cada uno llevaba a los esclavos a regiones diferentes explica muy probablemente el origen de las dos introducciones [de la malaria] que muestran los datos", explica el estudio. El trabajo termina con un continuará, pues apunta a que la posterior inmigración a América desde "el sur de Europa y Asia" pudo traer consigo nuevas variantes minoritarias de la enfermedad.


Comentarios de nuestros socias/os
¿Quieres comentar?Para ver los comentarios de nuestros socias y socios, primero tienes que iniciar sesión o registrarte.